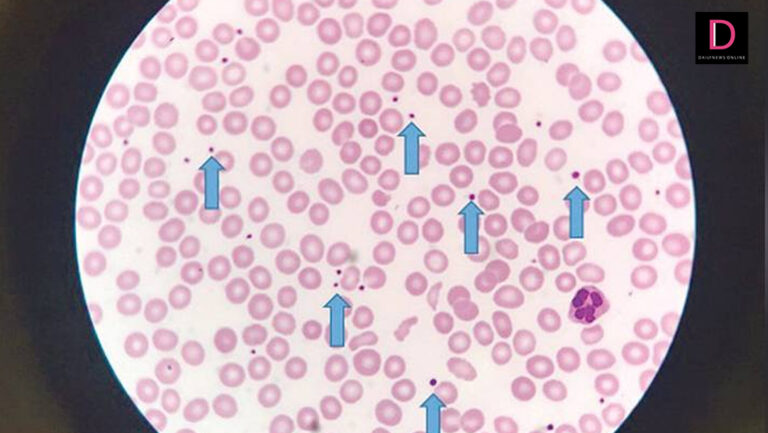
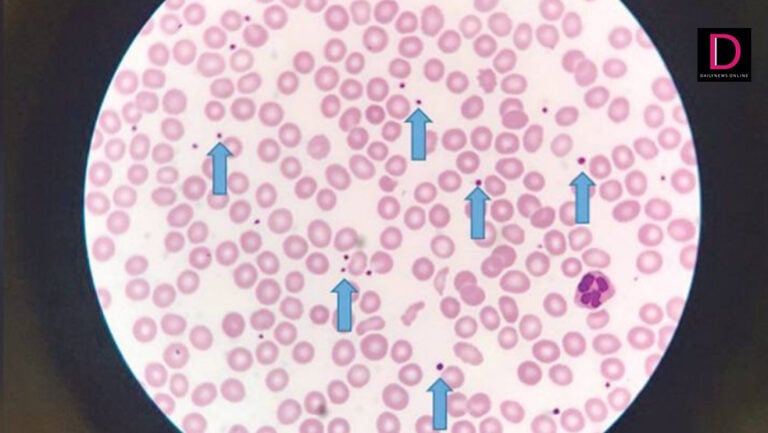

บทความล่าสุด


คำเขียน-คำอ่านในหลวงร.10 รู้ไว้ใช้อย่างถูกต้อง
27 กรกฎาคม 2562
9:00 น.

พระปิดตา บันดาลโชคลาภ มีกินมีใช้สมบูรณ์
6 กรกฎาคม 2562
9:09 น.
“จ้ำเลือดตามผิวหนัง เสี่ยงเลือดออกง่ายในผู้ใหญ่”
11 พฤศจิกายน 2561
8:30 น.
“จ้ำเลือดตามผิวหนัง เสี่ยงเลือดออกง่ายในผู้ใหญ่”
11 พฤศจิกายน 2561
8:30 น.

กล็อก 9 มม. พัฒนาล่าสุด Glock 19 Gen 5
6 ตุลาคม 2561
9:00 น.

กล็อก 9 มม. พัฒนาล่าสุด Glock 19 Gen 5
6 ตุลาคม 2561
9:00 น.

“เจแปน” ไอดอลเด็กฟิล์ม แรงบันดาลใจสู่รุ่นน้องสายหนัง
22 เมษายน 2561
3:00 น.

“วันกองทัพอากาศ” เน้นค่านิยมหลัก “AIR”
9 เมษายน 2561
7:00 น.

“เจแปน” ไอดอลเด็กฟิล์ม แรงบันดาลใจสู่รุ่นน้องสายหนัง
23 เมษายน 2560
3:00 น.

โรคแปลกที่ควรรู้จัก โรคเลือดข้นและเกล็ดเลือดสูง
12 มีนาคม 2560
4:15 น.

โลกอีกใบของสาวฉายเดี่ยว!!‘มิ้นท์-มณฑล กสานติกุล’เมื่อชีวิต ‘เสพติด..การเดินทาง’
22 พฤศจิกายน 2558
5:29 น.




